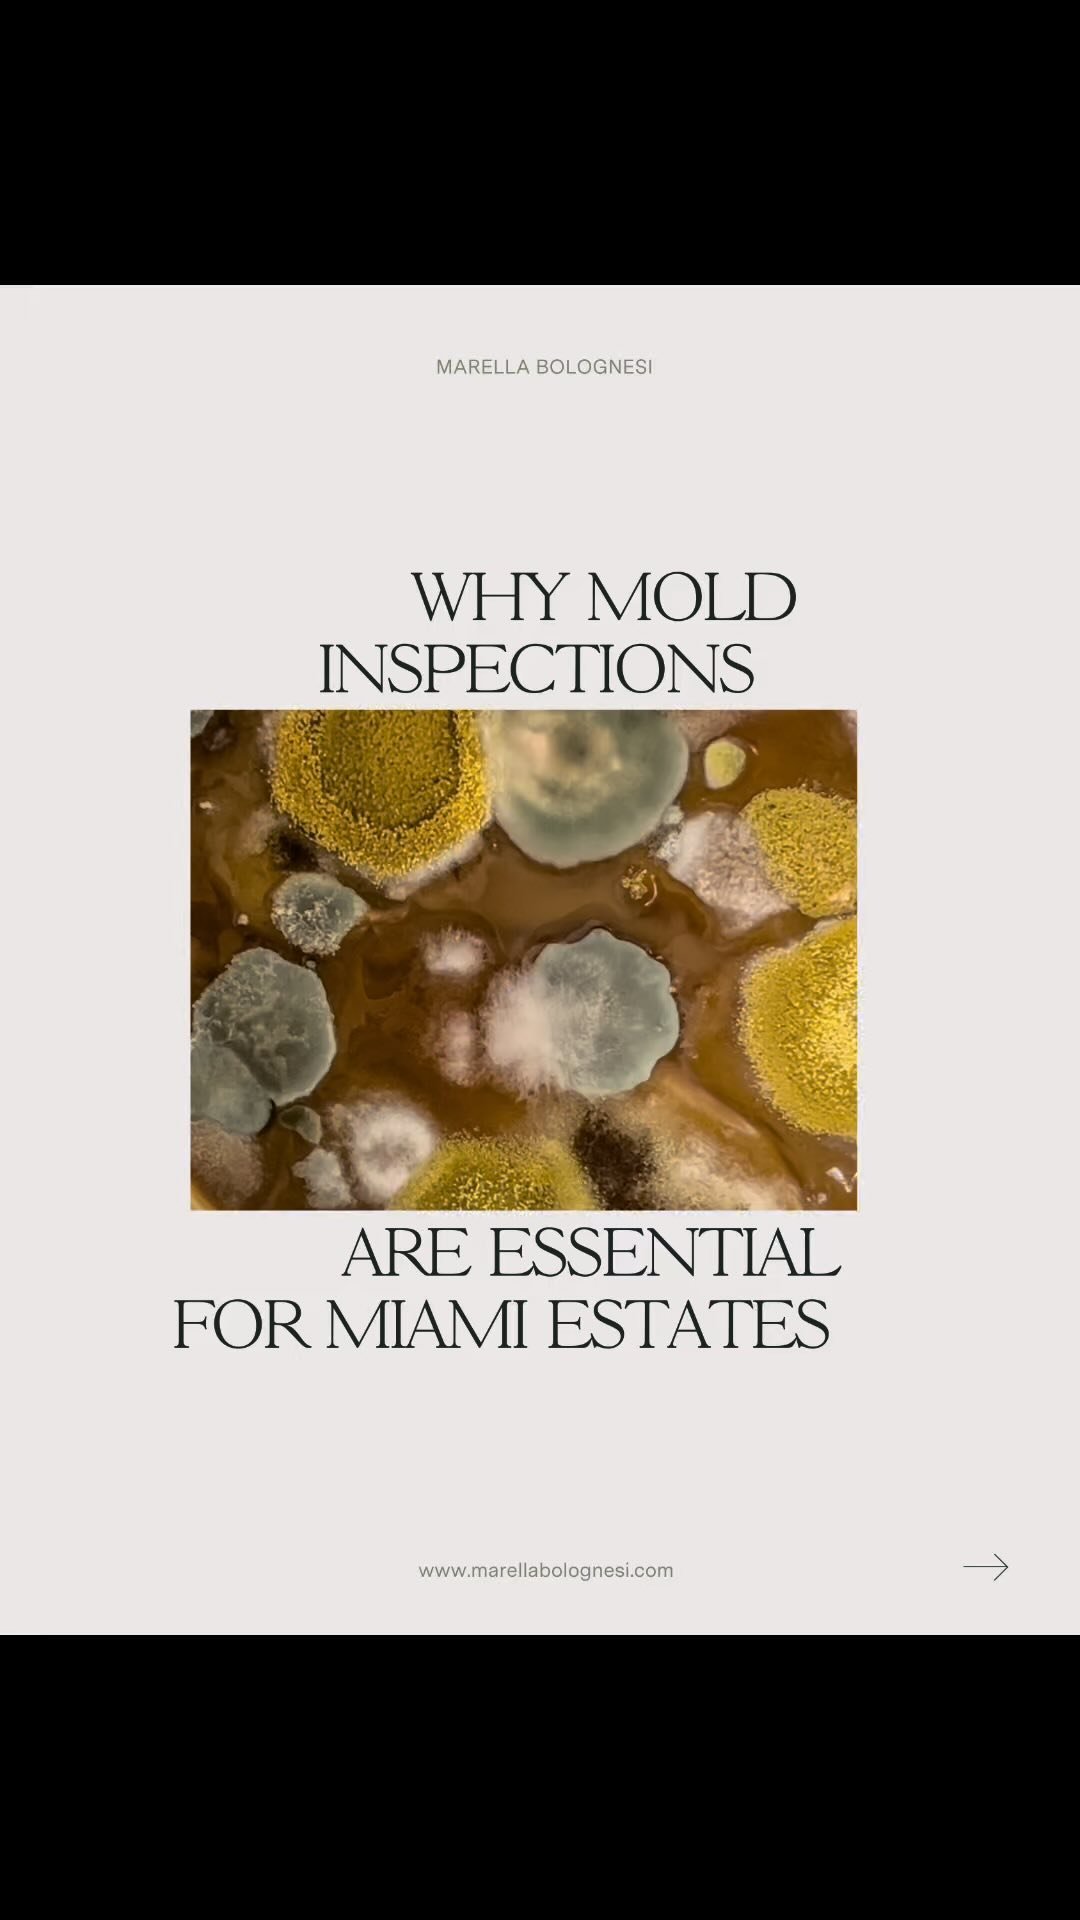

FREE DOWNLOAD
Hurricane Preparedness Checklist for Estate Managers
A digital checklist to safeguard high-value properties. This is the exact checklist I use to manage celebrity and luxury properties, ensuring that absolutely nothing is overlooked.
Do not try to build this checklist from scratch..
LEAN ON THIS TRIED AND TRUSTED PLAN AND AVOID:
(01)
Feeling overwhelmed by the complexities of hurricane preparation.
Risking costly damages by overlooking critical protection measures.
(02)
Compromising property safety due to incomplete preparation.
(03)
Wasting valuable time and resources on inefficient planning.
(04)
Facing potential legal liabilities from inadequate hurricane response.
(05)
WHAT’S INSIDE:
(01)
A detailed checklist covering every aspect of hurricane preparation
(02)
Home preparation tips before hurricane hits
MEET THE FOUNDER
Hi, I’m Marella Bolognesi
FROM EMPLOYEE TO FRELANCER TO ESTATE MANAGER FOR UHNW INDIVIDUALS, I’VE BEEN WHERE YOU ARE NOW..
I’m happy to give you this tested checklist that takes something as daunting as the hurricane preparedness of a luxury estate and turns it into a no-sweat, “I got this”, service you can proactively offer clients both existing and potential.
This checklist will help you
(01)
Significantly reduce preparation time with easy to follow steps.
(02)
Benefit from expert-backed strategies for maximum protection.
(03)
Turn a nerve-wracking responsibility into a simple, system-driven service, where you can breathe easy.
(04)
Get a professional edge over the competition.